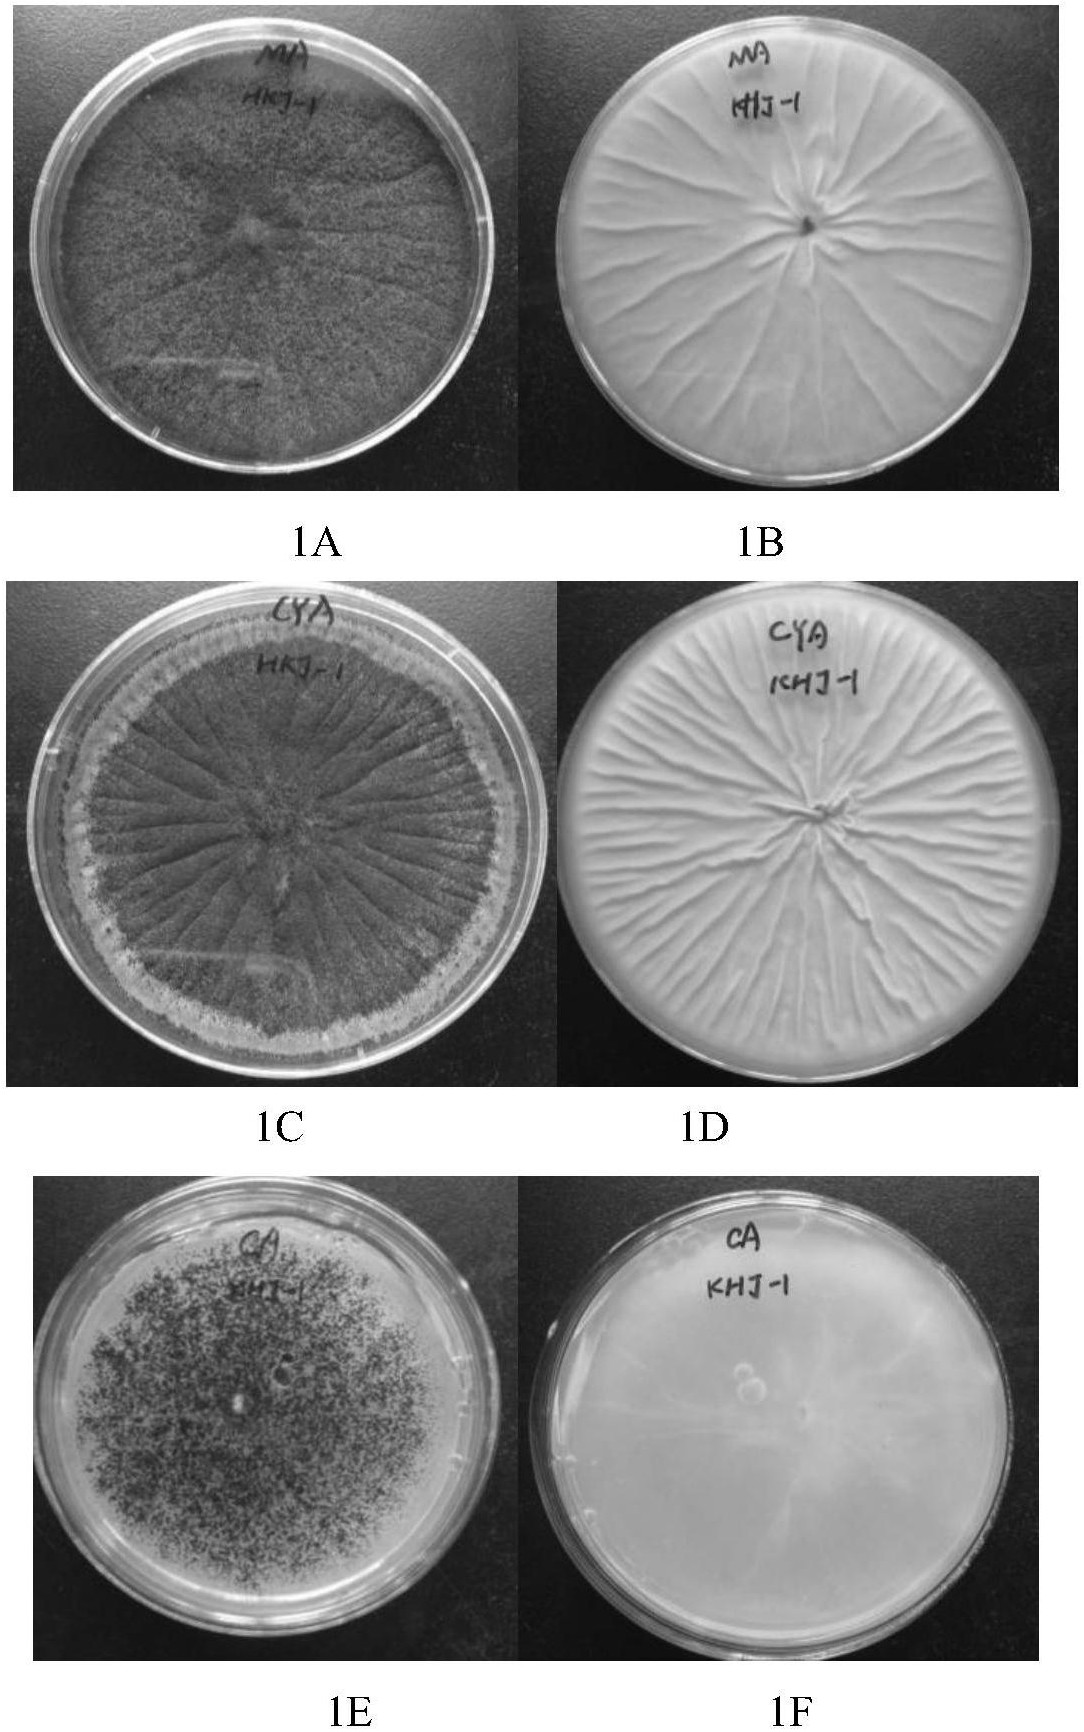
该菌种定名为:黑曲霉(aspergillus niger),已于2017年10月31日提交

Aspergillus niger

aspergillus niger 黑曲霉
图片尺寸4896x3672
黑曲霉(aspergillus niger sp.
图片尺寸490x396
fungi aspergillus niger, black mold
图片尺寸424x283
【预订】cellulases by aspergillus niger in solid
图片尺寸267x400
【预售 按需印刷】aspergillus niger as a noble biological control
图片尺寸907x1360
【预订】cellulases by aspergillus niger in solid state
图片尺寸500x500
fungi aspergillus niger on colorful background, black mold
图片尺寸1500x1101
预订aspergillus niger as expression host for protein
图片尺寸267x400
按需印刷】isolation of citric acid producing aspergillus niger
图片尺寸907x1360
of citric acid by locally isolated aspergillus niger using
图片尺寸913x1360
spergillusniger van tieghem,在金针菇,蘑菇,平菇等食用菌栽培中是一
图片尺寸500x400
production from oleaginous fungal strain aspergillus niger
图片尺寸800x800
【预订】zur kenntnis der lipase von aspergillus niger (van tiegh
图片尺寸500x500
海外直订citric acid production by aspergillus niger 黑曲霉产柠檬
图片尺寸800x800
海外直订directed evolution of the aspergillus niger epoxide
图片尺寸800x800
p>黑体尖陶乐鲶, i>oxydoras niger /i> (valenciennes, 1821), a
图片尺寸640x480
and characterization of xylanse from aspergillus niger 黑曲霉产
图片尺寸800x800
该菌种定名为:黑曲霉(aspergillus niger),已于2017年10月31日提交
图片尺寸1084x1732
2016英国gq年度人物盛典精彩回顾
图片尺寸1620x1069
董琛,李丹丹,张志勇,等.
图片尺寸1575x1457